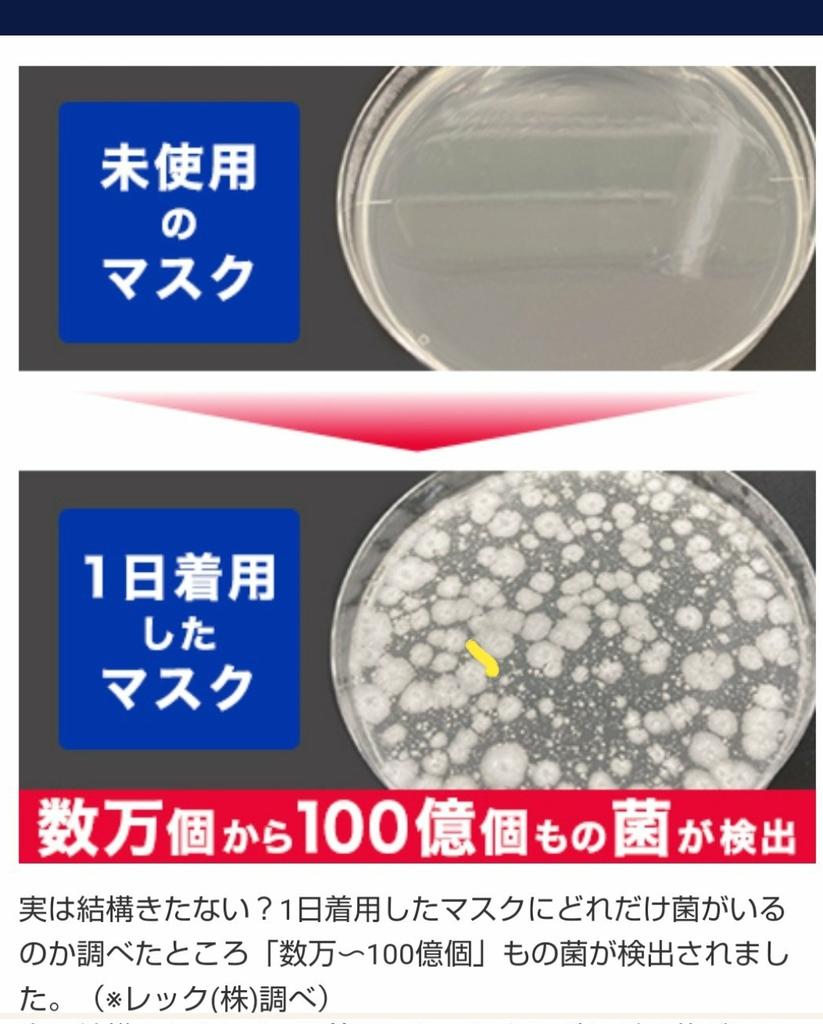

1
結局 日本人って 何も考えてない人が大半なんですよ。
マスクもテレビの言うまま。学校の先生の言うまま。まわりの人に合わせてるだけ。
日本人は 想像以上に頭の中は空っぽですよ。
脳味噌が入ってたら30年も景気が悪いなんて事になっていません。
2
昨夜 友人と居酒屋でマスク論争になった。
友「マスクは人に感染させない為にするって知ってる?」
僕「マスク着用率 世界1位2位3位の日本 台湾 韓国が
感染者数 世界1位2位3位になり 感染した99%以上が マスク着用者って知ってる?
マスク効果ゼロ所か 害悪じゃん」
友「・・・」
3
「マスクを着けてない方には 販売しません」と 昨年 僕を追い出した メロンパン屋。閉店しました。
片や 店員さん全員素顔 お客さん9割以上素顔の 魚料理屋さんは大行列。
マスクなんか着けて陰気臭い店より 笑顔で「いらっしゃいませ~」と元気で明るい店に行きたくなりますよ。
4
反ワクでも無かったのに コロナワクチンのせいで 他のワクチンも 本当に効果なんかあるのか?と 疑ってしまう様になったのは 僕だけではないと思う。
5
コロナ平均死亡年齢/85.28歳
全死因平均死亡年齢/82.65歳
これを知っても コロナが怖いと言う人は 心療内科へ GO!
コロナ死者の平均年齢は全死因死者より2歳上 agora-web.jp/archives/22121…
6
この3年リアルに
「マスク着けなきゃダメだよ」
「マスク着けてください」
「マスクお持ちですか?」
「着けてない方は 入店出来ません」
などと言われてきたけど 言った本人と言わせた人は「馬鹿な事を言ったな…」と反省してもらいたいね。
7
#WBC
これをホラーと言わず 何と言いましょう?
気持ち悪い。
最初からアメリカで開催して貰いたかった。
8
9
ワクチン打たない人
マスクを着けない人を 未だに「陰謀論にハマってる」と言う人がいますね。
世界を見てごらんよ。
コロナを怖がってる あなたが「陰謀論にハマってしまったんですよ」
10
僕の住む「市」は コロナ終わる気配があるな。
外を歩く人の6~7割は素顔。
スーパーや飲食店入店時も素顔が増えてきた。
全国的にも早い方じゃないかな?
11
リアルで「ワクチン打ちました?」「マスクした方がいいですよ!」と 未だに言ってくる人に「コロナごっこは 好きな人だけで やってくれい!」と 強目にズバッと言うと 黙って何も言わなくなる。
ワクチン打たない理由や マスク着けない理由を 話するのも面倒臭い。
12
何一つ 感染対策しない事が 一番の感染対策。
日本人は いつ気づく?
13
「ノーマスク ノーワクチン 旅行も行って 遊んでる奴ら」と 揶揄するツイートを見たけど 健康な人が 普通の生活してるだけなんだよね。
14
マスクを製造してる方々は ご存知ですが 隙間の大小 衛生面等の基準は有りません。
雑貨です。
虫取網のようなマスク。
不織布マスク。
基準など 何も有りません。
「感染対策の為にマスクの着用をお願いします」
???
業界人からしたら 日本語が崩壊してるレベルです。
15
「マスクは感染を防ぐものではありません」と殆どの商品の 注意書に記載されている 雑貨品。
なぜ 厚労省が推奨するのか? さっぱりわからない。
#マスク効果ない
16
フードコートで 食べながら 話をしてる人達は 怖くないのに 数十メートル先の 食品売場でマスクしてない人が怖くなる人は どういう理屈なのかしら?
17
・マスクの穴とウイルスサイズを知ってもダメ
・ウイルスはエアロゾル感染だから意味がないもダメ
・マスクは便器並みに汚いもダメ
・マスク着けてる人は精神障害もダメ
・熱中症になるもダメ
・マスクを外そうCMもダメ
・世界中マスクしてないもダメ
日本人 恐るべし😫
18
世界の7割程度がコロナ止めたら日本も止めると楽観視してた。
まさか残り3ヵ国に入ると思わなかった。
19
この1ヶ月で個人商店のメロンパン屋とおにぎり屋に「マスクしてない方はお引き取りください」と帰らされました。
非常に気分が悪く 最初から行きたくないので
「◯◯県◯◯市の ◯◯店は マスクしてない人には販売しない店」
と 皆さんと情報共有出来ませんか?
20
とにかく企業の「マスク着用のお願い」を直ぐに止めて貰いたい。
マスクを着けさせられるのでは?とホテルの予約も躊躇する。
21
この暑い中にPCR検査に並んでる人達、誰よりも元気だな。
22
「一体、何を観て聞いたらコロナが怖くなったんだよ?」と友人に聞いてみた。
恥ずかしいのか?黙る。
25
マスクしてない女性は凛としていて綺麗ですな~